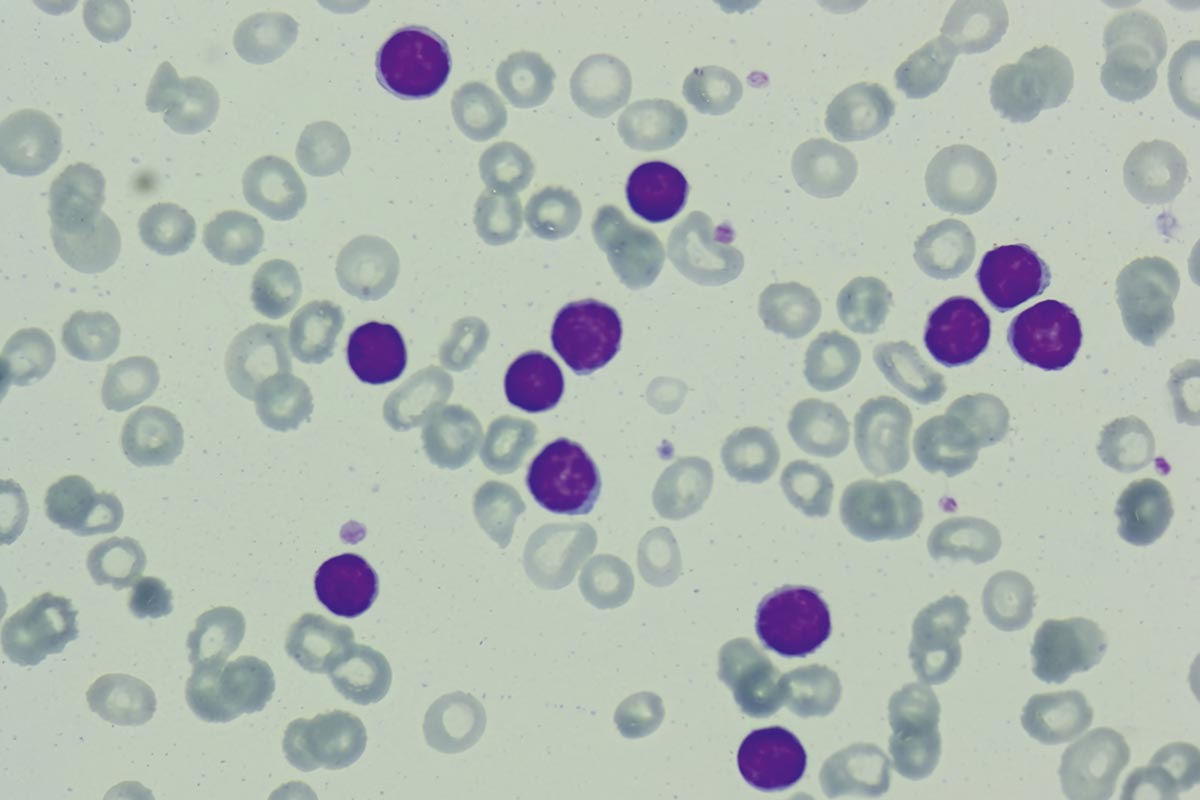
Зрелые лимфоциты в мазке крови. Источник: Alparslan Merdin et al. / Clinical Case Reports, 2017

Мы привыкли думать об иммунной системе как о войсках. Но чтобы толпа вооруженных клеток не привела организм к распаду, ей нужно отличать своих от чужих и не нападать на них, а если уж напали — уметь тормозить.
Люди с врожденными дефектами иммунных тормозов страдают не меньше людей с иммунодефицитом. Им не приходится жить в изоляции от мира, чтобы ничем не заразиться, но неприятности у них начинаются иногда до появления на свет. И тех, и других обычно спасает только трансплантация. А вот что именно им нужно трансплантировать, почему нынешние нобелиаты так долго это искали и кому еще оно поможет, сейчас расскажем.

Мэри Э. Бранков, Фредерик Рамсделл и Симон Сакагучи. Источник: NobelPrize
Кто сказал «стоп»
Симон Сакагучи подозревал, что среди иммунных клеток должны быть те, кто запрещает другим лимфоцитам работать. Потому что в его экспериментах аутоиммунные болезни у мышей предотвращались переливанием крови или одной только ее Т-клеточной фракции от здоровых сородичей. А значит, рассудил он, в здоровой крови есть какие-то Т-лимфоциты, которые мешают иммунной полиции атаковать своих.
Раньше считалось, что эту проблему решает тимус. В нем созревают и обучаются Т-клетки (собственно, поэтому «Т-»), и важная часть этого обучения — отсев. Каждый лимфоцит несет рецептор только к одному антигену, и те из них, кто связываются со здоровыми белками, которые им показывают в тимусе, там и погибают. Этот феномен называют центральной толерантностью.
Когда здоровым мышам удаляли тимус через несколько дней после рождения, у них развивался целый букет аутоиммунных патологий: страдали желудок, яичники и щитовидная железа. Гибель собственных клеток организма — обычно дело рук Т-лимфоцитов, а значит, среди тех, кого тимус успел выпустить в кровоток до удаления, все же осталось сколько-то опасных недоучек.
А раз переливание крови от этого помогает, значит, в норме существует еще и толерантность периферическая, и какие-то клетки могут остановить полицейский беспредел уже на местах. Оставалось только эти клетки найти.
Под микроскопом все лимфоциты на одно лицо. Различать надо по белкам на поверхности: например, на мембране Т-киллеров есть молекула CD8, а у Т-хелперов — CD4. Но какие белки сидят на «Т-супрессорах», никто не знал. Получился замкнутый круг: чтобы выделить клетки из крови и изучить их, нужно заранее знать, за какие белки хватать.
Зрелые лимфоциты в мазке крови. Источник: Alparslan Merdin et al. / Clinical Case Reports, 2017
[su_note note_color=»#e8e8e8″] Лимфоциты обеспечивают приобретенный иммунитет:
В-клетки стреляют по противнику антителами издалека,
Т-киллеры цепляются за подозрительные антигены на поверхности клеток,
Т-хелперы узнают антигены и активируют Т-киллеров, подтверждая, что антигены правда подозрительные,
NK-клетки держатся особняком; они тоже отличают собственные клетки от чужих или сломавшихся, но используют для этого белки главного комплекса гистосовместимости[/su_note]
Сакагучи не был первым, кто взялся за эту работу. Иммунологи удаляли тимус и переливали кровь мышам еще в 1960-х, когда он еще заканчивал школу. В 1970-х, пока он учился в университете, они пробовали выловить из крови те самые «Т-супрессорные клетки». Но для этого не хватало ни точности методов, ни молекулярных знаний.
Например, когда Сакагучи защитил диплом и присоединился к поискам этих клеток, ученые обнаружили, что белки, характерные для Т-супрессоров, кодируются в I-J локусе генома. Но уже в 1982-м, одновременно с тем, как Сакагучи защитил диссертацию по Т-супрессорам, оказалось, что в I-J локусе никакого гена нет. Многие иммунологи из этого сделали вывод, что и Т-супрессоров не существует.
Но Сакагучи продолжил поиски — почему-то же переливание Т-клеток спасает мышей от аутоиммунных болезней. Метод, которым он действовал, выглядел так: Сакагучи обрабатывал мышиные Т-лимфоциты антителами к разным поверхностным белкам и потом вводил их мышам с удаленным тимусом. Если у мышей начинались аутоиммунные проблемы, значит заблокированный белок связан с миротворческой деятельностью Т-клеток, и к нему стоит присмотреться повнимательнее.

Источник: nobelprize.org
Таким путем к 1982 году он определил два характерных белка: CD5 и CD45. Но они встречаются на всех Т-клетках, и на роль идентификатора не годились. Третьего кандидата Сакагучи нашел 13 лет спустя, в 1995-м, — им оказалась молекула CD25, она встречалась только на каждом десятом Т-хелпере.
Сейчас мы знаем, зачем регуляторным Т-клеткам CD25. Это рецептор интерлейкина-2, мощного провоспалительного сигнала (который активирует лимфоциты). Оказавшись в очаге воспаления, Т-регуляторы собирают на себя молекулы ИЛ-2, чтобы те не достались Т-киллерам.
Это свойство Т-регуляторов тормозит воспаление, но оно же затормозило и работу Сакагучи: поскольку ИЛ-2 в норме действует на Т-киллеры, у них тоже есть рецепторы к нему, и чем дольше бьет набат, тем этих рецепторов больше. Поэтому за несколько дней воспаления все Т-киллеры покрываются CD25.
Так что и эта молекула оказалась не уникальной, доказательством существования Т-регуляторов не стала, и квест Сакагучи продолжился.
Где у него кнопка
У двух других нобелиатов этого года не было пятнадцати лет на поиски нужного белка. Они работали в биотехе, где время течет гораздо быстрее. Сотрудники Celltech Chiroscience искали лекарство от аутоиммунных болезней — и потому разбирались, что сломалось в организме «паршивых» мышей (линия scurfy).
Эту линию модельных животных вывели в середине прошлого века на Манхэттенском проекте, когда изучали влияние радиации на организм человека и других млекопитающих. «Паршивыми» мышей назвали изза характерных проплешин на коже вокруг ушей и глаз. Это результат воспаления кожи — одного из многих аутоиммунных процессов в их организме. Кроме того, у них поражены селезенка и печень, а умирают они в первые недели жизни от кровотечения в кишечнике.
Правда, гибнут только самцы — самки остаются здоровыми, «парша» обходит их стороной. Поэтому Бранков и Рамсделл знали, что природа болезни — генетическая, а поломка лежит где-то на Х-хромосоме. У самок Х-хромосом две, и даже если от матери ей досталась «паршивая» мутация, то здоровая отцовская хромосома компенсирует ее эффект.

Сверху: здоровая мышь. Снизу: «паршивая» мышь.
Источник: Eva N Hadaschik et al. / Arthritis Research & Therapy (2015)
Бранков и Рамсделл взялись найти этот ген. Если бы им удалось выяснить, для чего он нужен и с каким процессом связан, можно было бы запустить этот процесс у людей с аутоиммунными болезнями. В то время поиски генов были устроены гораздо сложнее, чем сейчас: ученые и раньше искали, что сломалось у «паршивых» мышей, но им не хватало ни методов секвенирования, ни базы данных — найденный ген было бы не с чем сравнить.
Но на 1990-е, когда Бранков и Рамсделл взялись за несчастных мышей, пришелся бум секвенирования. В разгаре был проект «Геном человека» (Human genome project, HGP), и мышиную ДНК тоже секвенировали в параллель. Поэтому будущим нобелиатам хватило и методов, и материалов.
Впрочем, задача все равно была не из легких: мышиный геном еще не был готов, и они искали свой ген вручную. Для этого они скрещивали мутантных самок со здоровыми самцами, их потомство — опять со здоровыми. В результате таких скрещиваний получается набор мышей, унаследовавших разные участки Х-хромосомы от мышей scurfy, и, следовательно, позволяет судить, какой именно связан с аутоиммунной «паршой».
После того как Бранков и Рамсделл сузили поле поиска до 500 тысяч пар оснований, они перешли к секвенированию, чтобы выяснить, есть ли на нем гены и за что они отвечают. Гены нашлись: какие-то были известны, но один оказался новым. Это было в 2001 году — геном мыши еще не расшифровали, а HGP опубликовал только один черновик ДНК человека. Так что Бранков и Рамсделлу пришлось искать, на какие известные гены похож их новооткрытый. Они заключили, что тот кодирует какой-то ДНК-связывающий белок. Его назвали Foxp3.
Вместе с этим будущие нобелиаты решили подробнее изучить аутоиммунный синдром IPEX, похожий на мышиную «паршу». Это врожденное заболевание, которое проявляется у младенцев в первые месяцы жизни. У них страдают в основном кожа, кишечник и поджелудочная железа (развивается диабет первого типа), но могут быть поражены и другие органы. Дети с IPEX умирают ко второму-третьему году жизни, если не получают пересадку костного мозга. Бранков и Рамсделл выяснили, что проблемы детей с IPEX вызваны тем же, чем и страдания мышей scurfy: мутацией в человеческом аналоге Foxp3.
В этот момент их путь наконец пересекся с многолетним маршрутом Сакагучи. Японец шел снаружи внутрь: он отталкивался от клеточной функции и искал, какой белок за нее отвечает. Бранков и Рамсделл двигались ему навстречу: нашли ген, выделили белок, а потом стали разбираться, чем именно в организме они занимаются. В 2003 году они убедились в том, что действительно стоят в одной точке.
Сакагучи прочел работы своих американских коллег и обнаружил, что Foxp3 активен в его Т-регуляторах (к тому времени их стали называть именно так, чтобы лишний раз не вызывать в памяти споры о «Т-супрессорах»). Более того, он показал, что можно запустить Foxp3 в обычных Т-хелперах и тем самым превратить их в Т-регуляторы. Так выяснилось, что Foxp3 управляет судьбой Т-лимфоцитов и запускает их дифференцировку в Т-регуляторы.
В том же году Рамсделл с коллегами продемонстрировали, что в организме мышей scurfy не хватало именно Т-регуляторов. Так Т-регуляторные лимфоциты получили уникальный маркер и признание научного сообщества, а люди с синдромом IPEX — подробное описание причин и механизмов своей болезни. Но до решения Нобелевского комитета оставалось еще 22 года.
Сила убеждения
За это время иммунологи подробно разобрались в том, откуда берутся и чем заняты Т-регуляторные клетки. Например, стало известно, что не все они получают свою специализацию в тимусе, некоторые появляются уже в тканях из обычных Т-хелперов (но эти обычно работают не так эффективно). Кроме того, стало понятно, что отъем ИЛ-2 — не единственный способ, которым они могут повлиять на Т-киллеров.
Работа любого Т-лимфоцита начинается с встречи с антиген-презентирующей клеткой, которая демонстрирует, какие части белков ей попались в последнее время внутри ткани. Если лимфоцит узнает какой-то белок, он активируется и начинает действовать: Т-хелпер активирует Т-киллера, а Т-киллер отправляется искать клетку, которая этот белок произвела, чтобы ее уничтожить.
Примерно так же действуют и Т-регуляторы, только на них, в отличие от Т-киллеров, находятся рецепторы к собственным белкам организма. Они прилипают к антиген-презентирующей клетке и могут даже отобрать у нее антиген, чтобы он не попался никому на глаза.
Если же рядом оказывается Т-киллер, Т-регулятор может или украсть у него ИЛ-2, или, наоборот, выделить ИЛ-10 — противовоспалительную молекулу, которая не дает киллеру активироваться. К тому же на поверхности у Т-регуляторов встречается CTLA-4 — еще одна тормозящая молекула, за открытие которой дали Нобелевскую премию в 2018 году.
Иными словами, получается, что периферическая толерантность, которой ведают Т-регуляторы, заключается не в том, чтобы сделать невозможным полицейский беспредел, а в том, чтобы создать для него неблагоприятный фон. Технически Т-киллер все равно может атаковать ни в чем не повинную клетку, но не делает этого — потому что вокруг накапливаются Т-регуляторы, которые убеждают его этого не делать.

Как работают регуляторные Т-клетки (в центре)
А. Не дают дендритным клеткам (DC) активировать Т-киллеры;
В-C. Тормозят Т-киллеры с помощью внеклеточных пузырьков или противовоспалительных сигнальных веществ; D. Убивают Т-киллеры напрямую;
E. «Воруют» у Т-киллеров провоспалительные молекулы и выделяют свои тормозящие;
Источник: Payal Grover et al. / Frontiers in Immunology (2021)
Со временем стало понятно, что на этом работа Т-регуляторов не заканчивается. В жизни человеческого организма есть еще немало ситуаций, в которых нужно остудить пыл Т-киллеров и убедить их не вмешиваться.
Это, например, беременность, когда внутри материнского организма скапливаются чужеродные клетки, которые нельзя уничтожать. Или — заживление ран и регенерация: когда в поврежденной области накапливаются сломанные клетки, Т-киллеры принимают их за чужаков и могут сделать только хуже. Или даже ожирение: избыток жировой ткани вызывает в организме хроническое воспаление, и Т-регуляторы могут быть очень полезны, чтобы его притушить.
Все эти свойства могут сделать Т-регуляторы хорошим лекарством — безопасным и многофункциональным. С одной стороны, их можно прицельно «навести» на мишень, если речь идет об аутоиммунных болезнях вроде диабета первого типа или рассеянного склероза, когда Т-киллеры атакуют конкретный тип клеток.
С другой стороны, их можно использовать как универсальный иммуномодулятор, если нужно помочь заживлению раны или если в организме возникло хроническое воспаление, как это бывает при многих болезнях неиммунной природы, вроде болезни Альцгеймера или Паркинсона.
Такие лекарства есть, но ни одно из них еще не дошло до клиники, — как это часто бывает с открытиями, отмеченными Нобелевской премией. Нобелевский комитет вообще не гонится за практическими применениями — достаточно и того, что лауреаты убедили своих коллег немного иначе смотреть на мир.
Благодаря Сакагучи, Бранков и Рэмсделлу мы знаем, что иммунный ответ действует не столько по закону, сколько по ситуации. Не так важно, на кого нацелился воинственный лимфоцит, важнее — какие клетки столпились вокруг него и окажутся ли их голоса поддерживающими или, наоборот, отговаривающими. А клинические применения — дело времени и вопрос того, удастся ли последователям нобелиатов убедить Т-регуляторы поработать на благо пациентов.
